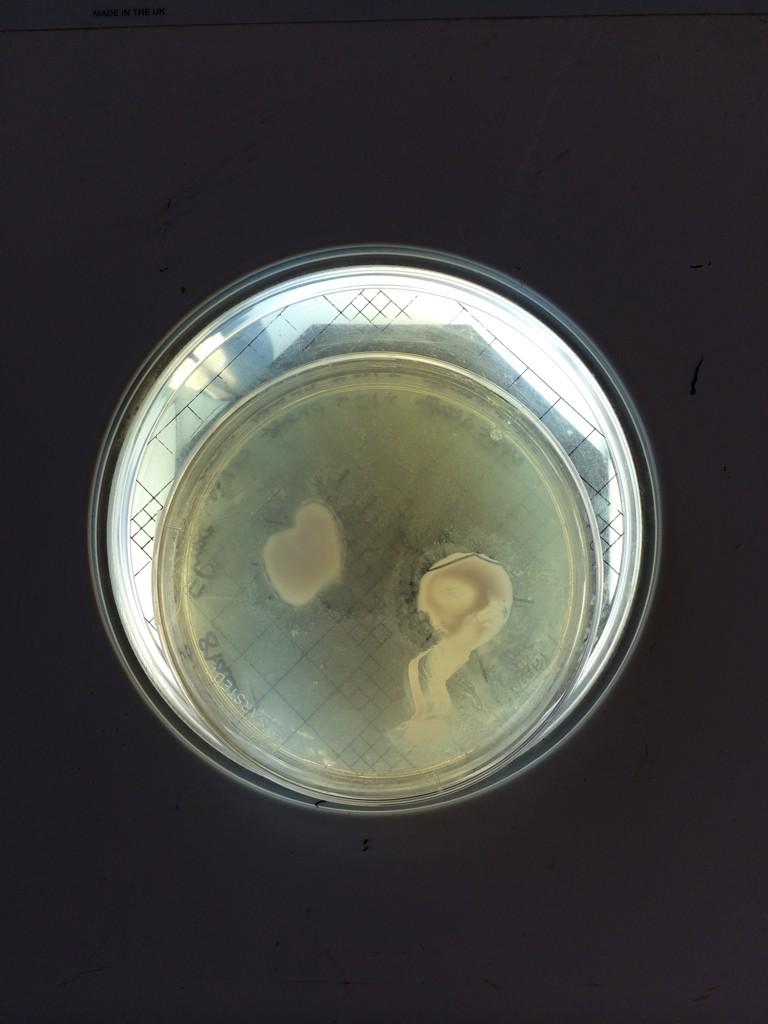
This is what 2 hours in a lab gets you! A plate with mist! #microbiologygeek #hailtoantimicrobialresistance 💊📈📖

Stacey Tylisczuk
@staceyliz4
Fitness First Bath and Exeter, BSc Human Nutrition undergraduate and sports nutrition fanatic.
ID: 839885372
22-09-2012 14:48:00
76 Tweet
76 Takipçi
125 Takip Edilen



love #FitnessFridays! Mud cleaned off and ready to smash session 2: chest and abs! There's no excuse not to get fitter and stronger Fitness First Bath

@ExtremeEventsUK Russell Payne Stacey Tylisczuk Tom Warry Theo Selassie oh my goodness I can't wait to see!!! 🙈


Feeling refreshed after the trial AGT sesh with Lee Drabble @FitnessFirstUK! Who would imagine 20 mins would be so hard Fitness First Bath loved it!

@G_H_i_g_g_i_n_s Lee Drabble @FitnessFirstUK Fitness First Bath Thanks Gary! Hopefully more opportunities to partake in his sessions then :D

#RedMonday Blaire Russell Payne Stacey Tylisczuk Active Health Claire Gorle Tom Warry @LantPeterPT


Not ashamed to be slightly addicted to CBB! I know she's no angel but I've really warmed to Katie Hopkins

19/1/15,most depressing day of the year? Not Fitness First Bath 3X more gym floor based classes Amy Pattenden Elliott page



Thanks to our friends @BTPcafes and Urban Fruit for keeping our #REDMONDAY guests fuelled. Much appreciated #WeCare



@ExtremeEventsUK Russell Payne haha oh Russ you know it!


@ExtremeEventsUK Russell Payne oh my god this is disgusting